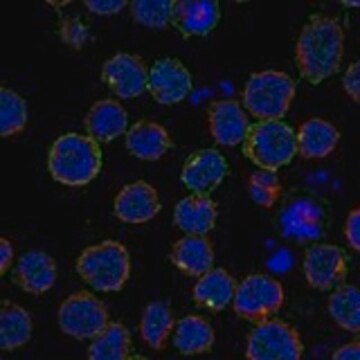
Anti-IL7R antibody produced in rabbit Prestige Antibodies® Powered by Atlas Antibodies, affinity isolated antibody, buffered aqueous glycerol solution

Anti-IL-7R antibody produced in rabbit
Synonym(s):
CD127 antigen, CDw127, IL-7R α, IL7RA, interleukin-7 receptor α chain
Products
Product Category
Brand
Biological Source
Clonality
Gene Alias
Isotype
Physical Form
Product Line
Antibody Form
Conjugate
Quality Segment
Post Translational Modification
Species Reactivity
Technique